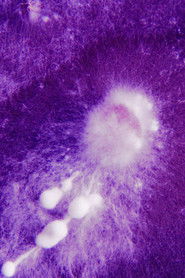
House of Spores

Dark Blossom
no information on the tagline
Director
No information
Writers
$0
Budget
$0
Revenue
08-05-2021
Release Date
DK
Country
-
Rating
-
Votes
-
Age Rating
80 min
Runtime
Released
Status
Urdu, Danish, English
Language
★ 0.0
$0
Budget
$0
Revenue
08-05-2021
Release Date
DK
Country
-
Rating
-
Votes
-
Age Rating
80 min
Runtime
Released
Status
Urdu, Danish, English
Language